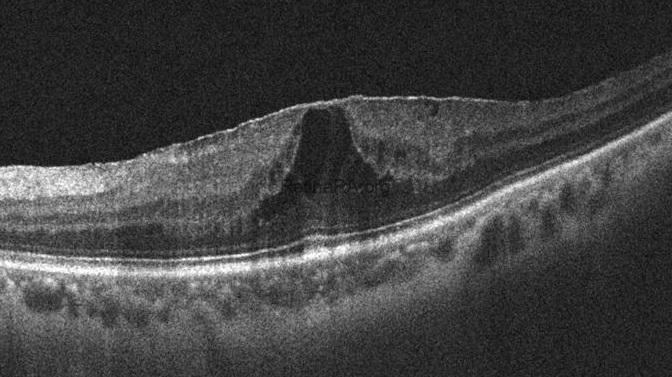

This post presents ERM+ILM Peeling In A Case With ERM-Foveoschisis.
A 54-year-old female patient whose left vision has decreased for the last 6 months. Visual acuity is 20/40 in the left eye. Anterior segment examination was unremarkable. OCT revealed an ERM-Foveoschisis. The ERM-Foveoschisis, earlier referred to as the lamellar macular hole (LMH) or tractional LMH, was classified as a distinct entity apart from the LMH. In contrast to the LMH, the neurosensory tissue loss is not a diagnostic feature in ERM-Foveoschisis. OCT also revealed a free edge of ERM and RNFL (white arrow).


The surgeon performed a vitrectomy surgery with ERM and ILM peeling. Because the Volk Super Macula contact vitrectomy lens was used during the peel, the image appeared upside down in the video. He emphasized that ERM peeling should not be started from the free end, as this may result in peeling of the free RNFL and RNFL loss. Pay attention to the yellowish color change in the fovea during the ERM peeling process. This indicated that the ILM was also peeled.
One month after surgery, foveoschisis disappeared, and a complete foveal depression occurred. The patient’s visual acuity had improved to 20/20.

Vitreoretinal Surgeon: M. Giray Ersoz, MD, FEBO
Memorial Bahçelievler Hospital, Department of Ophthalmology, Istanbul, Turkey
Arel University School of Medicine, Department of Ophthalmology, Istanbul, Turkey
Instagram accounts: @retina.review and @retina.dr.girayersoz
Website: www.girayersoz.com.tr
The YouTube video provides a detailed explanation of the surgery (click here to watch the video).